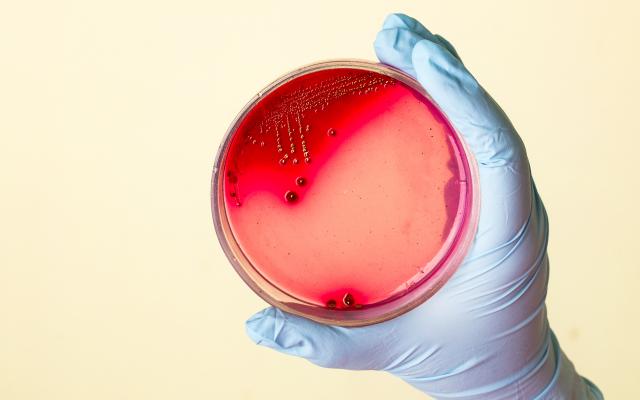
Een hand houdt een petrischaaltje vast.

Marlies van Houten is kinderarts, opleider en Principal Investigator in het Spaarne Gasthuis in Haarlem en Hoofddorp. Ze is mede-auteur van de Klinische Les over osteomyelitis bij kinderen in dit nummer (D6062).
Wat wilde u vroeger worden?
‘Op mijn tiende lag ik met een blindedarmontsteking in het ziekenhuis, met een grote rode B op mijn deur. Vanaf die tijd wilde ik kinderarts worden. Ik vond dat wat men in het ziekenhuis deed voor het zieke kind heel interessant. En die rode B wilde ik beter begrijpen.’
Welke levende arts bewondert u het meest en waarom?
‘Mijn collega en vriendin professor Lieke Sanders. Lieke heeft ongelooflijk veel kennis en kan dit op een eenvoudige manier met de patiënt en de omgeving delen. Daarnaast heeft zij altijd bewonderenswaardige keuzes gemaakt in haar carrière. Lieke is een rolmodel voor veel jonge, ambitieuze vrouwelijk dokters.’
Wat was de grootste vergissing in uw carrière?
‘Het niet aangaan van een fellowship waardoor ik binnen een vastgestelde periode meer de verdieping had kunnen zoeken.’
Wat was de beste stap in uw carrière?
‘Het starten van onderzoek op het gebied…

Reacties